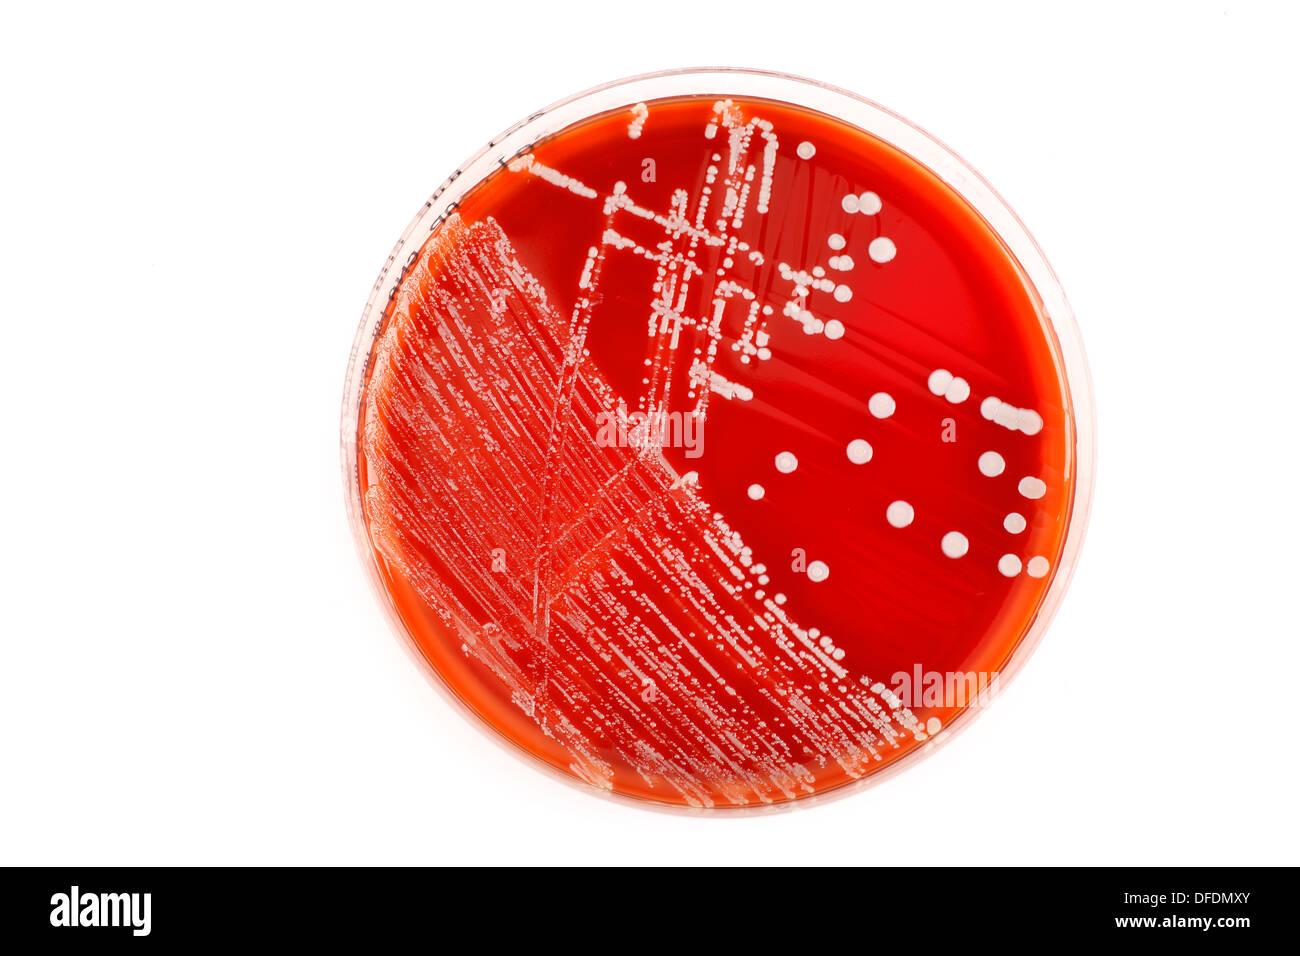
Boîte de pétri avec des bactéries rouge sur fond blanc Banque D'Images
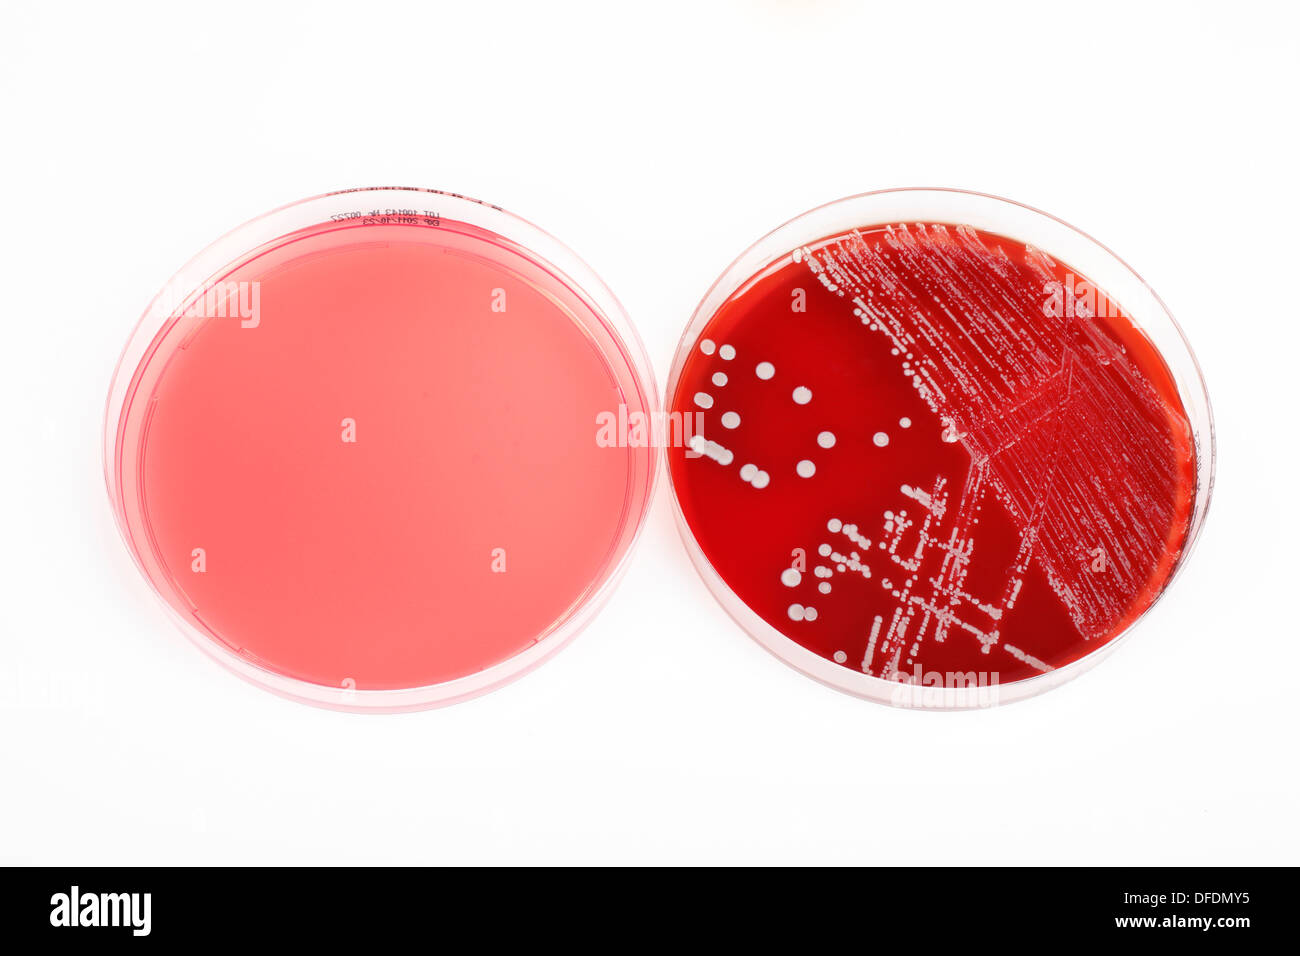
Deux dishs petri, un avec les bactéries et autres sans sur fond blanc Banque D'Images

Petri dish Banque d’images détourées
(2)Petri dish Banque d’images détourées
Boîte de pétri avec des bactéries rouge sur fond blanc Banque D'Imageshttps://www.alamyimages.fr/image-license-details/?v=1https://www.alamyimages.fr/boite-de-petri-avec-des-bacteries-rouge-sur-fond-blanc-image61152755.html
Boîte de pétri avec des bactéries rouge sur fond blanc Banque D'Imageshttps://www.alamyimages.fr/image-license-details/?v=1https://www.alamyimages.fr/boite-de-petri-avec-des-bacteries-rouge-sur-fond-blanc-image61152755.htmlRFDFDMXY–Boîte de pétri avec des bactéries rouge sur fond blanc
Deux dishs petri, un avec les bactéries et autres sans sur fond blanc Banque D'Imageshttps://www.alamyimages.fr/image-license-details/?v=1https://www.alamyimages.fr/deux-dishs-petri-un-avec-les-bacteries-et-autres-sans-sur-fond-blanc-image61152761.html
Deux dishs petri, un avec les bactéries et autres sans sur fond blanc Banque D'Imageshttps://www.alamyimages.fr/image-license-details/?v=1https://www.alamyimages.fr/deux-dishs-petri-un-avec-les-bacteries-et-autres-sans-sur-fond-blanc-image61152761.htmlRFDFDMY5–Deux dishs petri, un avec les bactéries et autres sans sur fond blanc